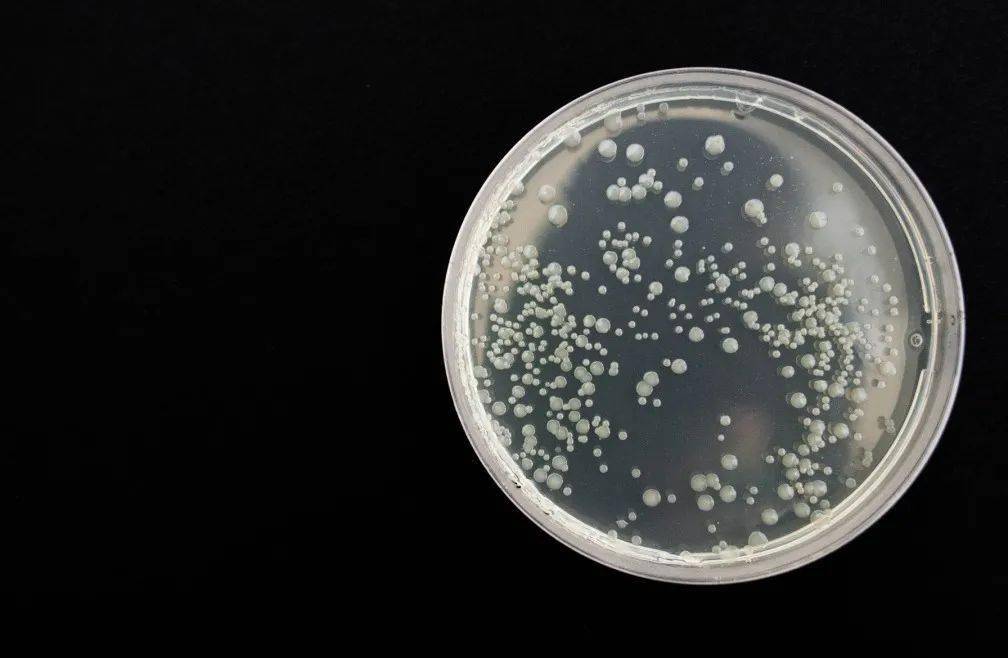
手上菌落实验：手上菌落不能超过几个

青松风雪之旅,完美攻略助你畅游无阻!
青松风雪,一个充满诗意和浪漫的词汇,描绘了一幅北国风光的壮美画卷,我们将为您带来一份详尽的青松风雪旅游攻略,带您领略这片冰雪世界的魅力。青松风雪地区概述青松风雪主要分布在我国北方地区,尤其是东北、内蒙古等地,这里冬季...
手上菌落实验:手上菌落不能超过几个
实验背景与目的在日常生活中,我们的手经常接触到各种物体,如门把手、手机、电脑键盘等。这些物体表面可能存在着大量的微生物,包括细菌、真菌等。为了了解我们手上的菌落情况,我们可以进行一项简单的手上菌落实验。这项实验的...
励志语录,点亮简历,成就非凡人生!
在当代社会,求职过程中的简历扮演着至关重要的角色,一份优秀的简历不仅能够展示求职者的专业技能与经验,更是其性格、态度与决心的展现,在这之中,励志语录的运用往往能为简历增添独特的色彩,彰显求职者的个人魅力,以下,我们将...
水密性规范:水密法施工规范
什么是水密性规范水密性规范是指为确保船舶、潜艇、水密容器等在水中能够有效防止水进入,从而保证船舶或容器内部干燥和安全的一系列技术要求和标准。这些规范通常由相关国际组织或各国政府制定,旨在保障航行安全、人员生命财产安...
放手前行,拥抱未来的励志力量
人生路上,我们总是在不断地追逐与坚持中前行,我们面临的选择并不是关于是否前进,而是关于是否放手,放手,是一种智慧,是一种勇气,也是一种成长,以下是一些关于放手的励志语录,希望能为你带来启示与力量。放手是成长的开始1、...
燃哥独家赏析,音乐、艺术与生活交融之美探索
在当今社会,我们身处于一个多元化、信息化的时代,音乐、艺术与生活紧密相连,共同构建着我们的精神世界,作为一位深度热爱音乐和艺术的人,燃哥以其独特的视角和敏锐的洞察力,为我们带来了一场场精彩绝伦的赏析,本文将通过燃哥独...
如何规范自己的社会行为:如何规范社会秩序
认识社会行为规范的重要性社会行为规范是维护社会秩序和谐稳定的基础,它涉及到我们日常生活中的方方面面。一个遵守社会行为规范的人,不仅能够得到他人的尊重和信任,还能够促进社会的和谐发展。因此,认识社会行为规范的重要性,...
精益生产驱动下的制造业实时监控与智能化升级之路实例解析
摘要:本文介绍了制造业实时监控的实例,展示了精益生产驱动下的智能化升级之路。通过实时监控,制造业企业能够及时发现生产过程中的问题并进行调整,提高生产效率和产品质量。这种监控方式有助于企业实现智能化升级,优化生产过程,...
二道白河镇实时天气及旅游指南
摘要:二道白河镇实时天气状况良好,适合旅游。游客可以根据天气预报选择合适的服装和行程安排。该镇拥有独特的自然风光和旅游资源,为游客提供丰富的旅游体验。如需了解更多信息,可查阅旅游指南。二道白河镇,这个位于吉林省长白山...

蜀ICP备2022005971号-1
蜀ICP备2022005971号-1